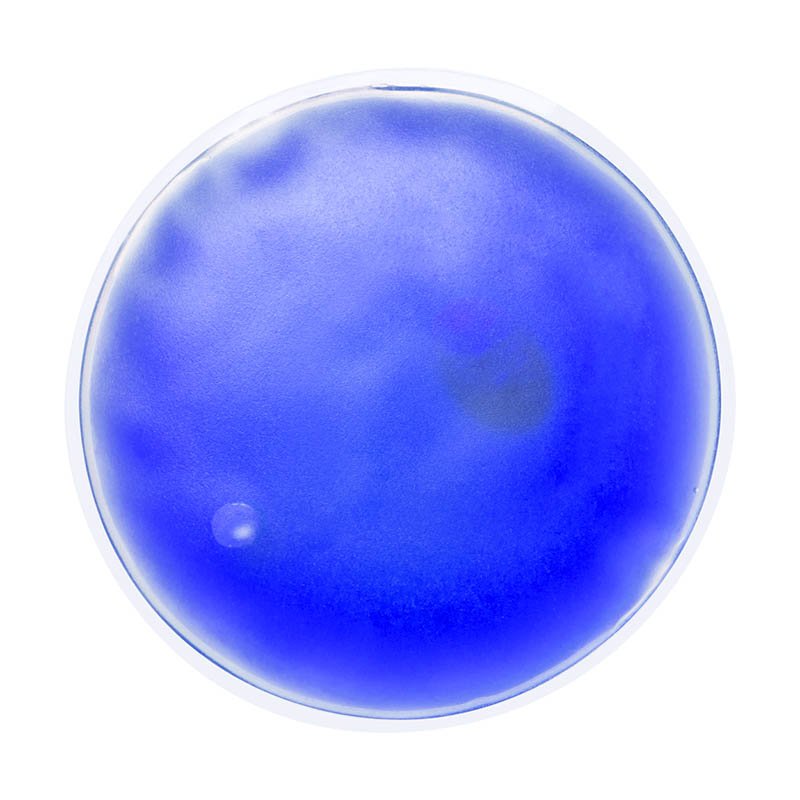

Transparentný hrejivý znovupoužiteľný vankúšik s farebným gélom.
| Materiál: | Plastic |
| Rozmer: | pr. 10 × 1 cm |
| Farba: | modrá |
| Minimálny odber: | 1 |
| Balenie Tovaru: | 200 |
| 10 830 ks: | môžete mať od 19.01.2026 (10:00 - 17:00) |
| 20 000 ks: | môžete mať od 26.03.2026 (10:00 - 17:00) |

Ohrievacie vrecúčko z PVC, generujúce teplo na základe stlačenia kovového pliešku umiestneného vo vnútri vačku. Produkt určený na reklamné účely. 88 x 110 mm

Oválný ohřívač rukou se aktivuje stisknutím kovové destičky uvnitř. Žádné baterie nejsou potřeba, znovu použitelné po provaření v horké vodě.

PVC hot/cold pack filled with water beads. Can be reheated or re-cooled after use by putting it in a pan with warm water or the freezer.

NOVINKA 2025. Thermal patch with heart design. Reusable and with a long-lasting heating effect. It is activated by bending the inside metal badge so that the patch hardens and heats up. For reusing, heat water in a pot with the patch inside until the inner gel returns to its liquid state. It will be ready to reuse by pressing the metal plate again. Instruction manual available in Spanish and English.

Hřejivá podložka ke zmírnění bolesti, křečí a stresu. Lze použít opakovaně. Nepotřebuje baterie.

NOVINKA 2025. Reusable thermal patch with cold and heat effect in varied colors and long lasting. For heat effect, heat water in a container with the patch inside. For cold effect, put the patch in the fridge or freezer.

Zahrievací, opakovane použiteľný, vankúšik v tvare srdca.

Pocket warmer WARM HEARTED: by flexing the metal plate and kneading, the heart supplies heat for approx. 20 minutes – before the next use, simply put the heart in very hot water for approx. 5 minutes. Please note that the logo application will come off af

Ohrievacie vrecúčko z PVC v tvare srdca, generujúce teplo na základe stlačenia kovového pliešku umiestneného vo vnútri vačku. 102 x 90 x 11 mm

Chladiaca alebo hrejivá podložka z PVC. Podložku nechajte vychladnúť v mrazničke alebo chladničke alebo ju vložte na niekoľko sekúnd do mikrovlnnej rúry, aby sa zohriala.